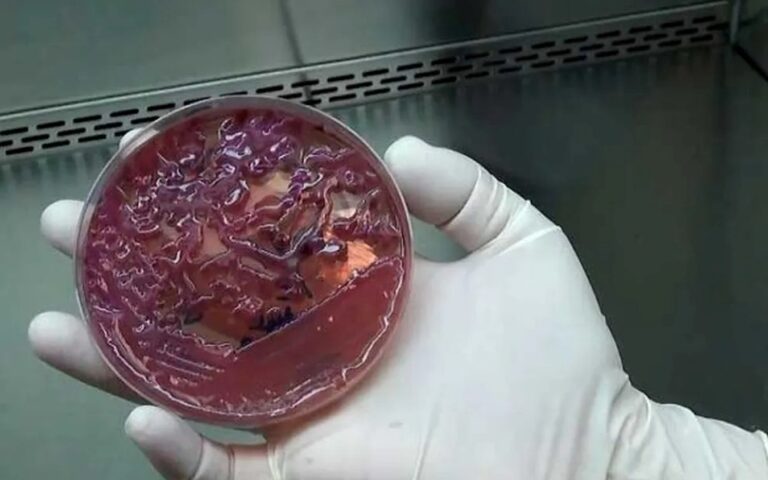
Reprodução - IEV

A narrativa tradicional das doenças emergentes costuma colocar a floresta como o berço de perigos desconhecidos que “transbordam” para a civilização. No entanto, uma nova e alarmante pauta científica inverte essa lógica: o ambiente urbano, marcado pela precariedade do saneamento, está funcionando como um exportador de “poluição biológica” para a biodiversidade. O fenômeno, chamado de “spillover” reverso, revela como bactérias de origem humana, já treinadas pela exposição a antibióticos nas cidades, estão colonizando rios e matas, transformando animais silvestres em reservatórios involuntários de genes de resistência. Na Amazônia, onde o déficit de tratamento de esgoto atinge índices críticos, essa troca invisível está criando o que especialistas chamam de “resistoma da floresta”.
Este ciclo perigoso é alimentado pelo descarte inadequado de resíduos farmacêuticos e dejetos humanos diretamente nos cursos d’água. Em muitas comunidades ribeirinhas e áreas rurais do Norte, a ausência de saneamento básico afeta mais de 93% dos domicílios. Quando o esgoto bruto alcança o habitat natural, ele não leva apenas carga orgânica, mas um exército de microrganismos multirresistentes. Animais generalistas, como roedores e primatas que se aproximam de assentamentos humanos em busca de alimento, acabam ingerindo essas bactérias. O resultado é uma “pandemia silenciosa”: a fauna nativa passa a carregar superbactérias que, futuramente, podem retornar aos humanos através da caça ou do contato direto, tornando medicamentos comuns ineficazes.
O resistoma da floresta e a ameaça à segurança alimentar
A investigação desse fluxo exige o uso de tecnologias de ponta, como a metagenômica, que permite mapear o conjunto de genes de resistência (o resistoma) presentes em um bioma sem a necessidade de cultivar cada bactéria em laboratório. O Plano de Ação Nacional de Saúde Única já aponta o enfrentamento da Resistência aos Antimicrobianos (RAM) como um macro-objetivo prioritário. A pauta jornalística aqui é urgente: ao “injetar” genes de resistência na Amazônia, a urbanização desordenada compromete não apenas a saúde animal, mas a segurança alimentar das futuras gerações que dependem da biodiversidade para o consumo de proteína e água.
Outro ponto de vulnerabilidade é o tratamento de animais silvestres como animais de estimação. Saguis e outras espécies, ao conviverem no ambiente doméstico, tornam-se pontes epidemiológicas. Eles trocam microbiota com humanos e animais domésticos, como cães e gatos, levando patógenos urbanos para o interior das matas. Esse contato facilita a disseminação de bactérias que já possuem mecanismos de defesa contra os principais antibióticos utilizados na medicina moderna. Assim, a degradação urbana atua como um motor de degradação biológica da floresta, fechando um cerco sanitário onde a saúde humana e a ambiental tornam-se indissociáveis.
O médico veterinário como guardião da fronteira sanitária
Nesse contexto de Saúde Única, a figura do médico veterinário ganha um papel estratégico que vai muito além das clínicas urbanas. Ele é o profissional capacitado para atuar na vigilância epidemiológica ativa, identificando patógenos circulantes na fauna antes que eles causem surtos em larga escala. Em áreas de fronteira e comunidades isoladas, o veterinário monitora o status sanitário dos animais, sendo essencial para o diagnóstico precoce de zoonoses como raiva e leptospirose. Sua atuação é o freio necessário para interromper o ciclo de transmissão entre a vida selvagem, os rebanhos domésticos e as pessoas.

SAIBA MAIS: Veneno de sapo amazônico revela escudo biológico contra superbactérias
Além da detecção, esses profissionais exercem uma função vital na educação em saúde e na segurança alimentar. Ao orientar comunidades sobre o manejo adequado de animais e o descarte correto de resíduos, o veterinário atua na prevenção primária da resistência antimicrobiana. Projetos de alta complexidade, como o Vivera, que monitora vírus em áreas de risco, contam com a expertise veterinária para mapear a saúde do ecossistema de forma integrada. Sem a presença obrigatória e o fortalecimento dessas unidades locais de vigilância, as lacunas sanitárias na Amazônia continuam abertas, permitindo que a poluição biológica avance sem controle sobre um dos biomas mais vitais do planeta.





Você precisa fazer login para comentar.